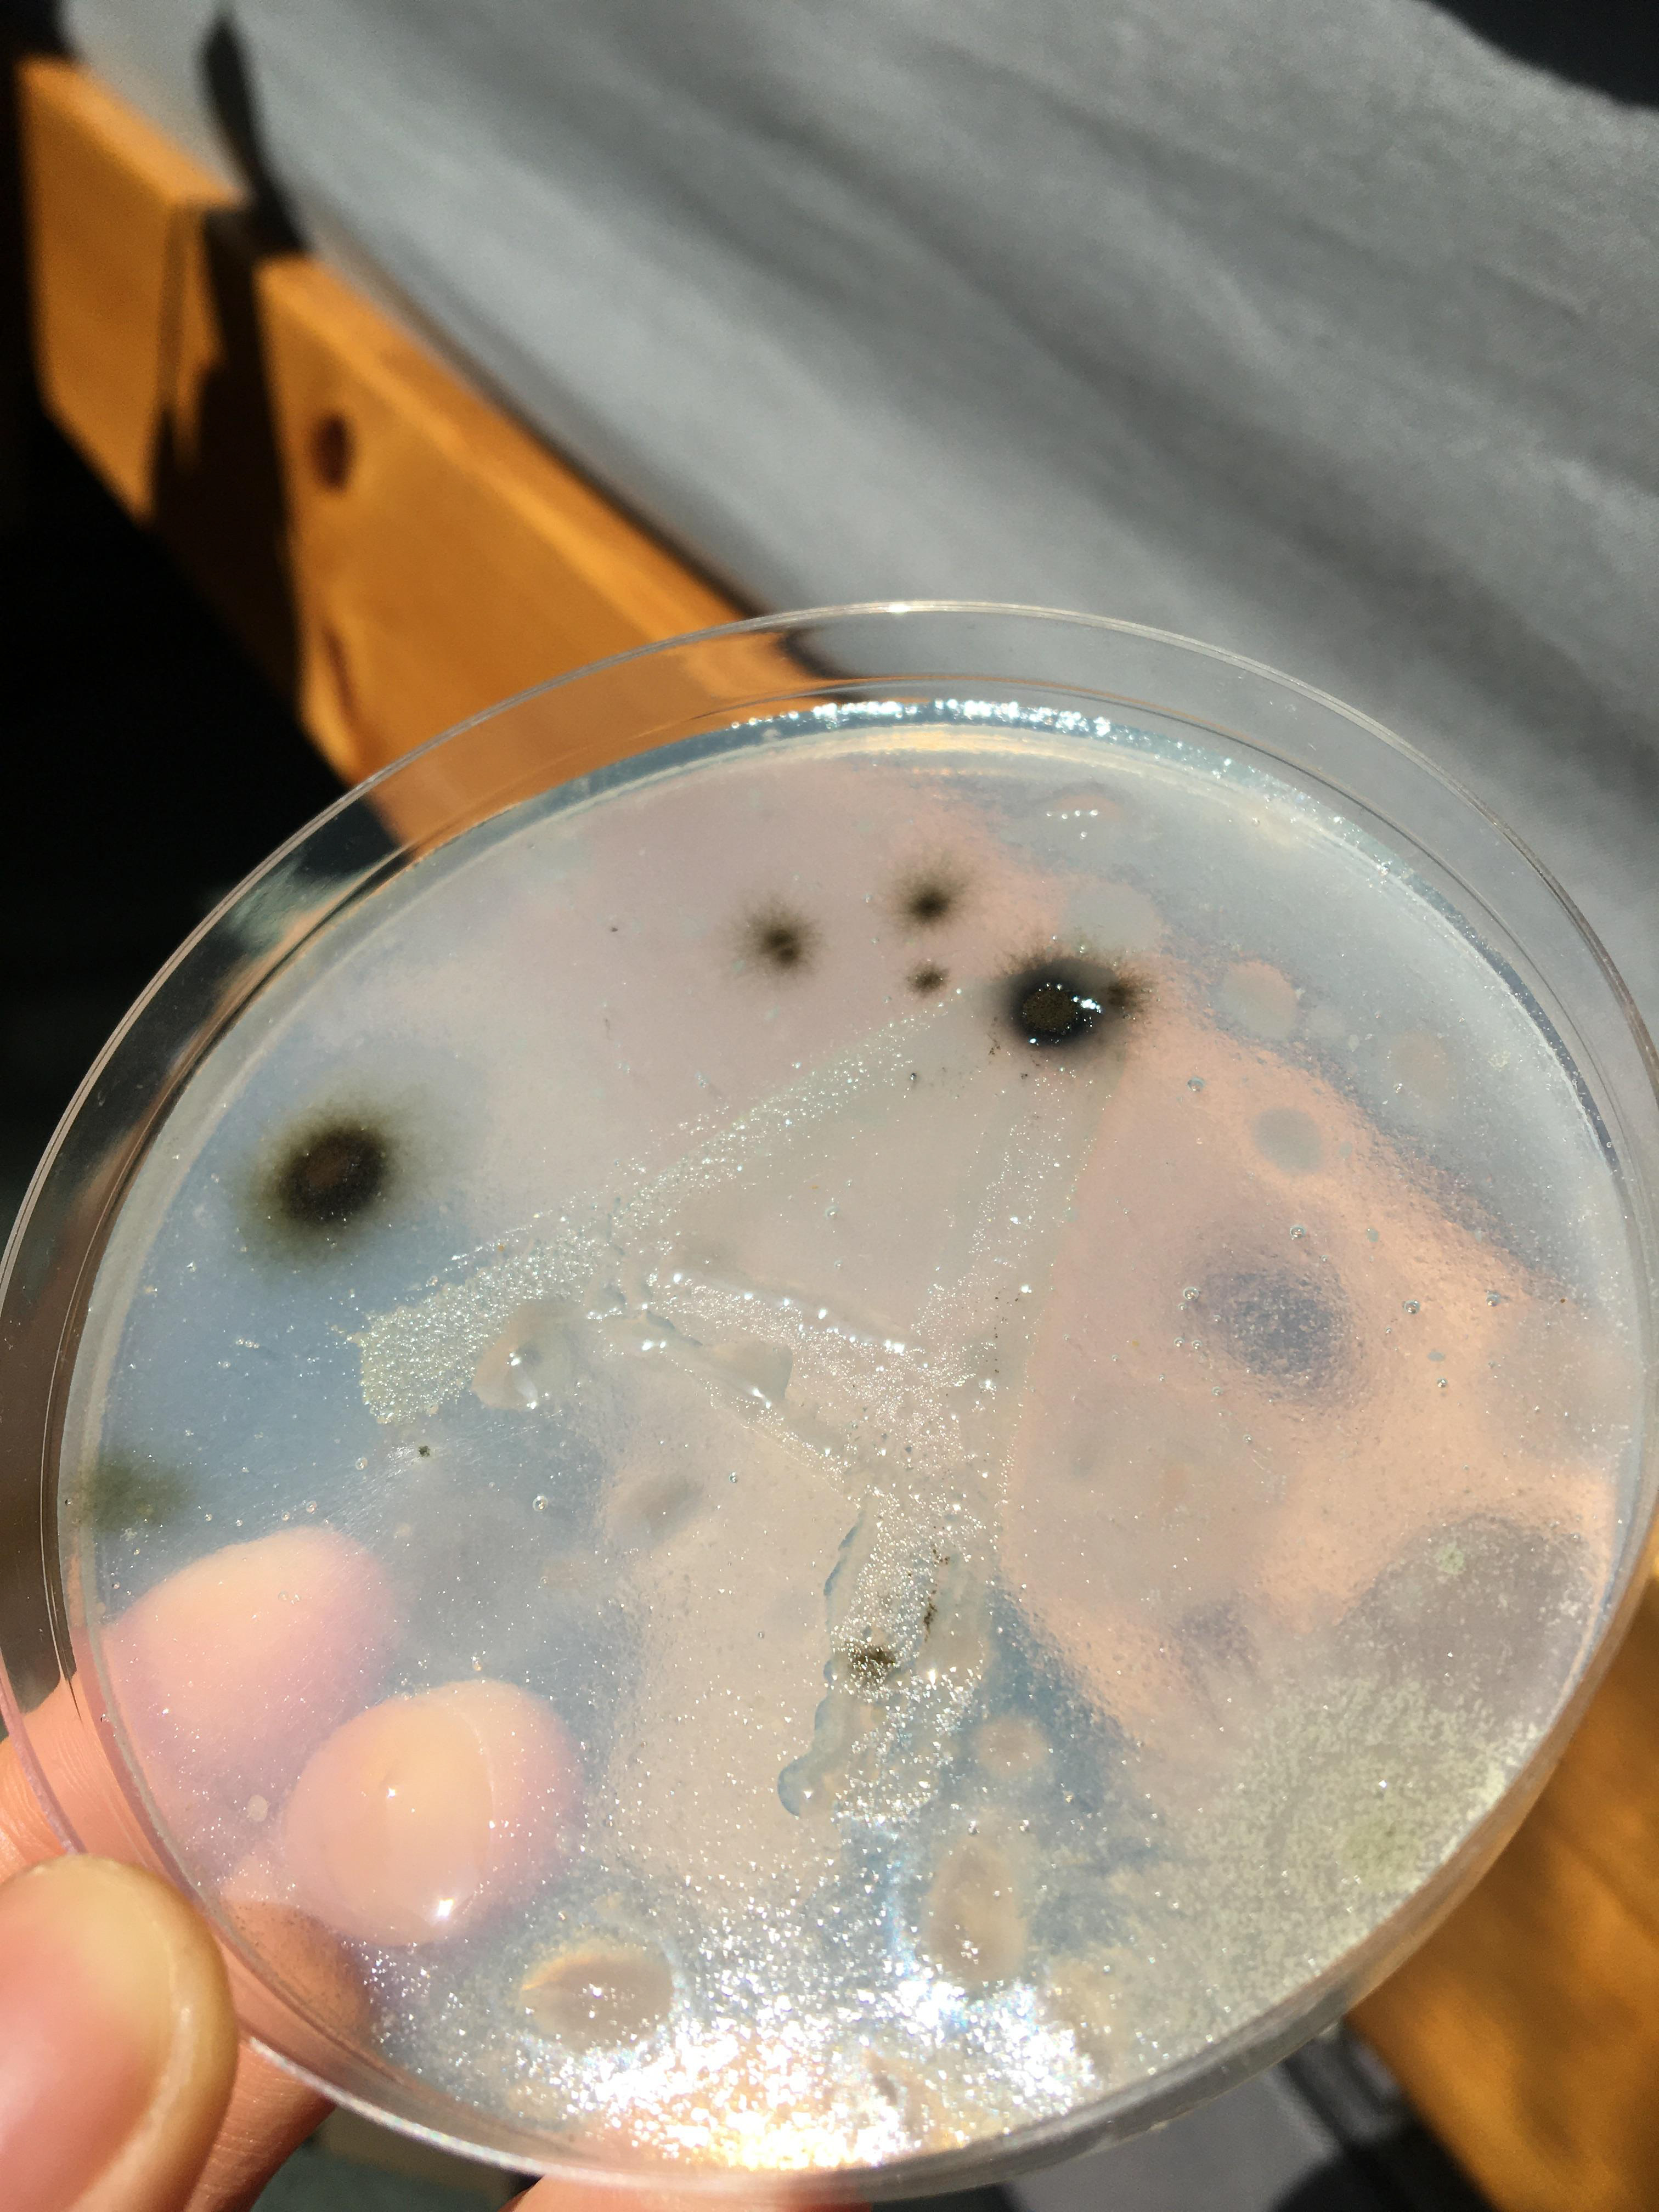

Bath Spa University - Year 3 Brief:
A self-initiated project with the aim of exploring the boundaries of typography in an experimental way, using different materials and technologies.



Liquid Distortion
One of my initial experiments which involved manipulating the type with different liquids. This created areas of magnification and distortion, creating an abstract outcome.





Typographic Arson
Here, I wanted to play with the idea of temporary typography and how it can evolve over time, from something which is clear and recognisable then becoming more abstract and obscure.




Processing
As the pandemic led to uni closing, I had to adapt my project to fit this change. As screen-based media would be more easily accessible than physical making, I decided to further explore and utilise Processing. Using results from my initial experiments, I played with 3D and mouse rasterisation to create abstract imagery.

Growing a typeface
I still wanted to develop physical making alongside my screen-based experiments. This led to covid inspired typography, created using agar plates and bacteria swabs. The typographic forms gradually grew and became visible on the surface- each reacted differently, producing intriguing results. I plan to explore this further as a personal project, now with a more informed approach.
The final outcome
The end result of this project was a website concept - below is the walkthrough of the design and function.

















